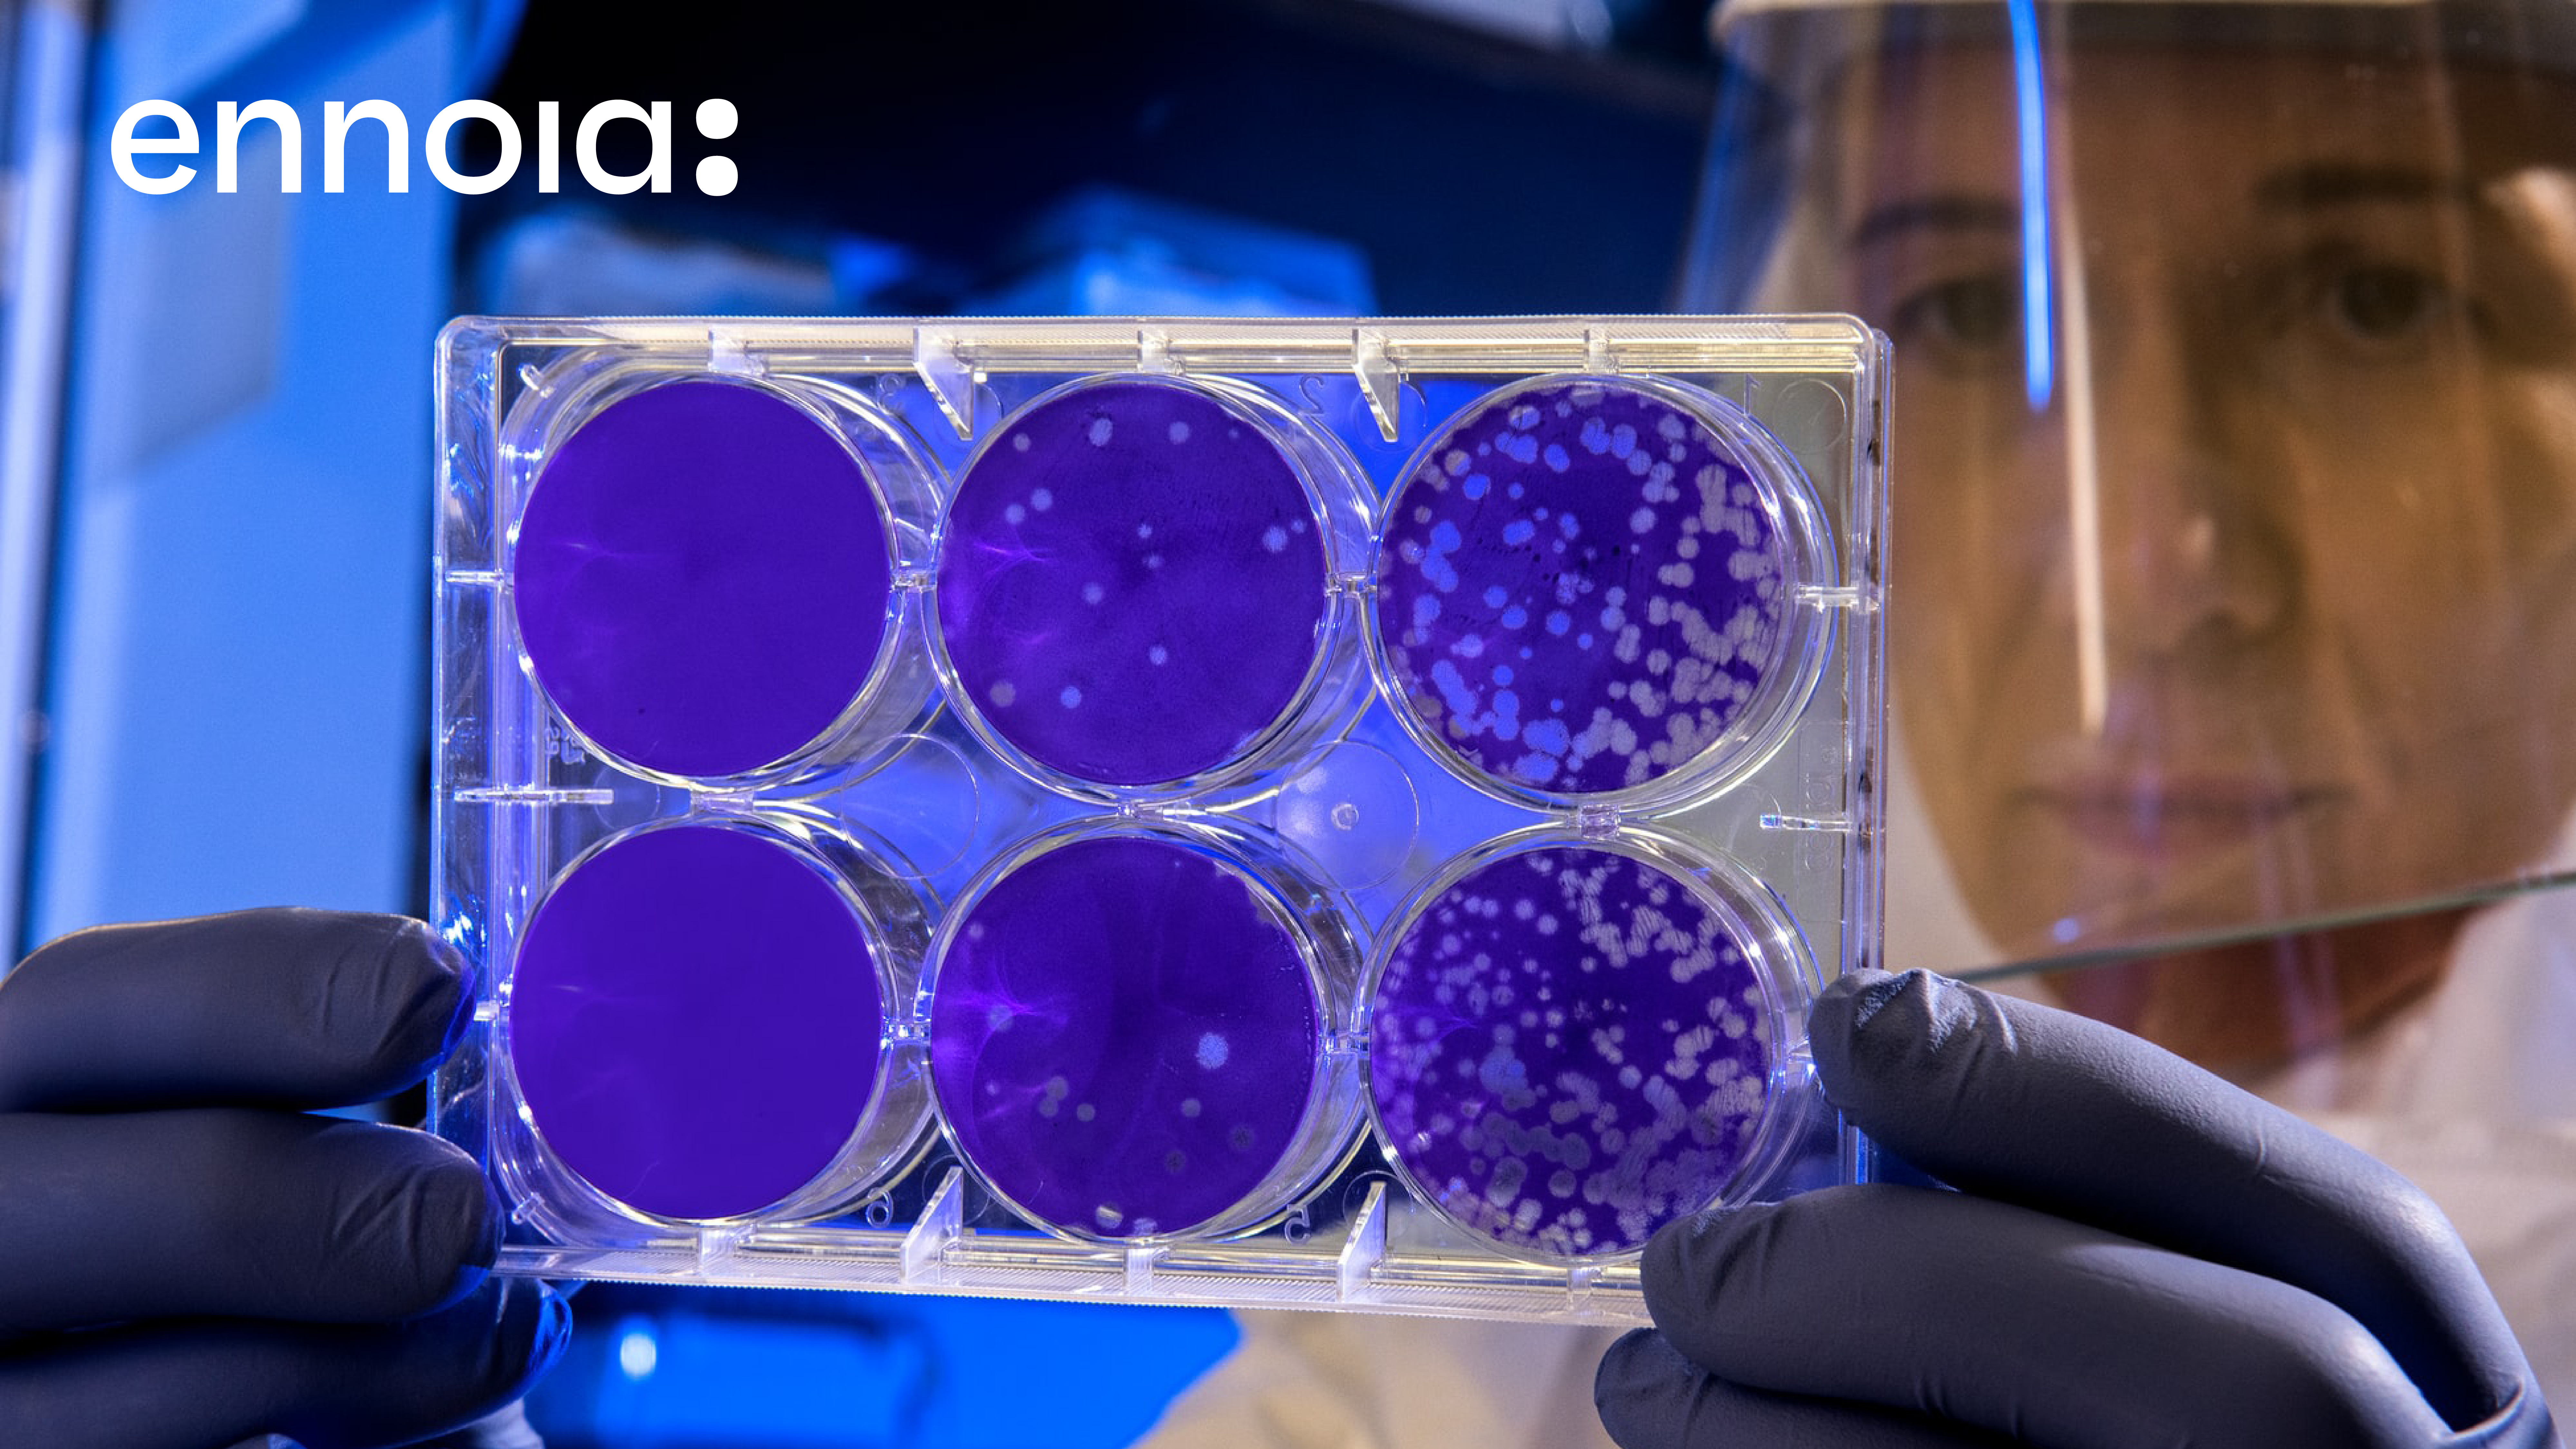

Ennoia
The Ennoia focuses on creating a clearer, more modern brand identity. The goal is to better communicate the brand’s values and vision through refined visuals, updated messaging, and a cohesive design system.

Up ↑
Radical simple solutions.
+48 505 409 844
hello@dominikrobak.com
Jaroslawa Dabrowskiego 30
02-561 Warsaw
Up ↑
Radical simple solutions.
+48 505 409 844
hello@dominikrobak.com
Jaroslawa Dabrowskiego
02-561 Warsaw